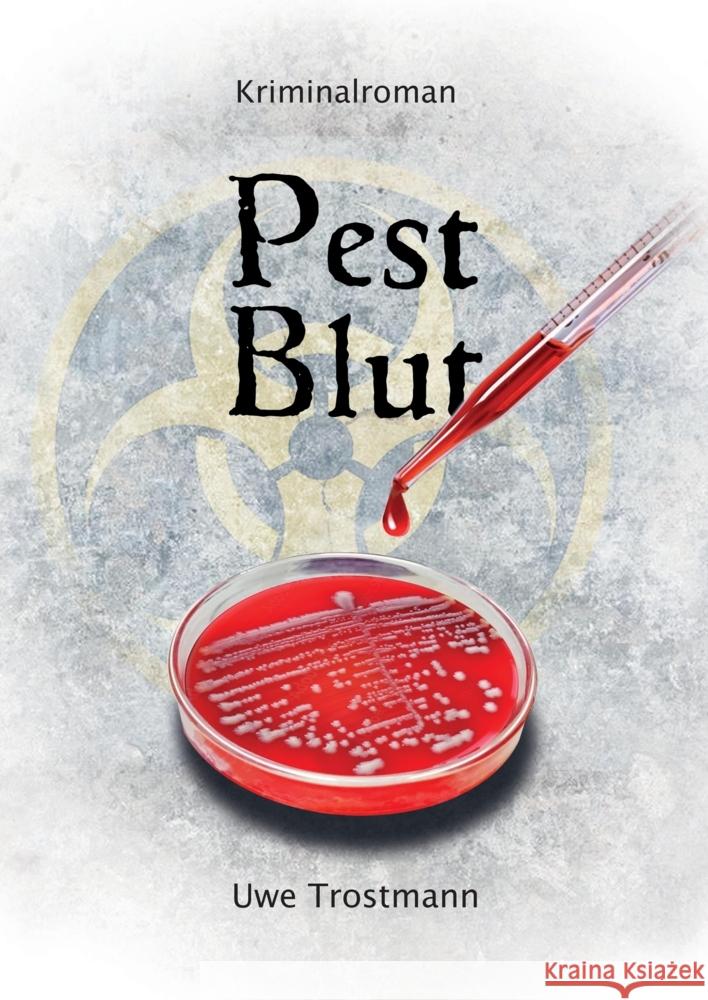
Pest Blut Trostmann, Uwe 9783347747234 tredition - książka

Pest Blut » książka
Pest Blut
ISBN-13: 9783347747234 / Niemiecki / Twarda / 400 str.
Ein Wissenschaftler wird im Labor ermordet, ein weiterer mit seinem Wagen von einer Brücke gestoßen. Beide arbeiteten an der Entwicklung von Antibiotika gegen Infektionen mit Pest-Bakterien. Während Chief Inspector Roberta Foster und ihr Team ermitteln, verseuchen gewaltbereite Mitglieder der Gruppe Green Spearhead einen Fluss mit tödlichen Mutanten von Yersinia pestis und dann das Trinkwasser eines kleineren Ortes. Die Terroristen wollen so die Summe von 100 Millionen Pfund und die Stilllegung pharmazeutischer Firmen erzwingen. Ihr Ziel ist eine neue Grüne Welt. Nur langsam gelingt es Foster und ihrem ehemaligen Chef, dem pensionierten Chief Inspector Steve Brennan, die Spur der Terroristen aufzunehmen. Als diese mit der Verseuchung des Trinkwassers von Birmingham drohen, beginnt ein Wettlauf mit der Zeit. Können Foster und Brennan weitere Anschläge mit noch mehr Pest-Opfern verhindern?